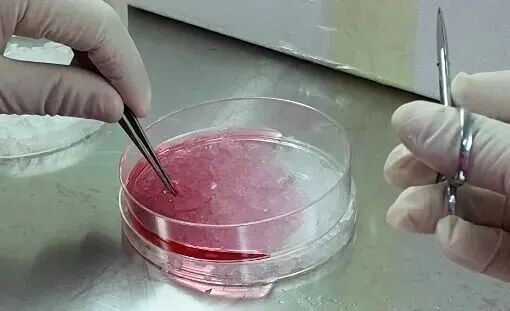

2025.09.19点击量:594
裸鼠皮下成瘤实验作为肿瘤研究领域的经典模型,通过将人类肿瘤细胞移植至免疫缺陷小鼠体内,为抗肿瘤药物筛选、免疫治疗机制研究提供了关键技术支持。

然而,实验中肿瘤生长不稳定、均一性差等问题频发,导致数据可靠性降低。
本文系统梳理5大核心问题及解决方案,结合标准化操作流程,助力研究者突破实验瓶颈。
一、五大常见问题
肿瘤先缩小后消失
炎症反应与细胞存活的双重挑战
实验中出现肿瘤先缩小后消失的现象,这主要源于两方面的机制:一是移植初期引发的局部炎症反应导致细胞被宿主吸收;二是接种细胞数量不足或活力低下。
若观察3周后肿瘤仍未复长,需更换免疫缺陷程度更高的小鼠(如NSG模型),其缺乏NK细胞、B/T细胞,可显著提升移植成功率。
肿瘤均一性失控
周龄与接种量的双重变量
正常情况下,部分肿瘤细胞(如黑色素瘤 B16)本身生长形态不规则,体积存在轻微差异(误差≤20%)无需干预。
若同组裸鼠肿瘤体积差异超过30%时,需重点排查两大因素:
周龄混养:4周龄与8周龄小鼠代谢速率差异显著,导致肿瘤生长速度不同步。
接种量偏差:细胞计数误差或注射技术不稳定(如部分小鼠注射量达5×10⁶,而其他仅1×10⁶)对于黑色素瘤等本身形态不规则的肿瘤,需建立误差容忍标准(≤20%),避免过度干预 。

生长迟缓困境
免疫抑制与细胞活性的平衡
当肿瘤生长速率低于预期时,可谨慎使用环磷酰胺(50mg/kg,每周1次)抑制裸鼠残留T细胞活性,进一步降低免疫排斥,从而加速肿瘤生长,但需严格把控剂量,否则可能出现:过度抑制,导致感染风险激增。
这种方法仅适用于常规成瘤失败案例,健康模型无需干预,同时建议同步检测细胞活力(台盼蓝染色)及支原体污染情况。
多点荷瘤禁忌
营养竞争与形态干扰的连锁反应
实验设计应坚持"一鼠一瘤"原则,单只小鼠多部位接种会引发三大问题:
肿瘤间血管生成竞争导致生长抑制;
机械挤压造成形态扭曲,影响体积计算准确性;
代谢负担加重,缩短小鼠生存期;

接种后无瘤
细胞、宿主与技术的三角排查
若7-10天仍未形成可见肿块,需重点排查:
细胞因素:活力检测(Trypan Blue排除率<5%)、成瘤能力验证(换用PC-3等高成瘤系)。
宿主因素:周龄优化(4-6周最佳),更换重度免疫缺陷的小鼠(Nod-scid或NSG替代裸鼠)。
技术因素:加入Matrigel基质胶辅助(1:1混合细胞悬液),增加注射的细胞数量或更换易成瘤的细胞系。
二、标准化操作流程
1. 细胞准备阶段
选用对数生长期细胞(密度80-90%)。
PBS清洗3次,去除血清干扰。
0.25%胰酶消化细胞后,用PBS或者无血清培养基重悬细胞并进行细胞计数,计算所需的终浓度。
细胞计数调整至终浓度:通常皮下瘤接种时,使用的细胞量为每支1-5×10⁶个细胞,接种体积为0.1毫升。
2. 细胞接种阶段
选用5-8周龄(18-20g)裸鼠,优先选择腋窝中后部、腹股沟中上部供血丰富区域进行接种。
在接种前,使用枪将细胞悬液充分吹散,以确保细胞均匀分散,防止细胞聚集降低其存活率。
注射前将细胞悬液放置在冰上,以减缓细胞凋亡。
用左手固定裸鼠后,45°角进针,深入皮下1cm后回抽,无血,再注射。
注射体积严格控制在100μl,推注时间>5秒。
3. 细胞接种后
接种完成每日观察小鼠活动状态及注射部位变化,大约1周后可以观察到肿瘤的形成。
肿瘤长出后,每日用游标卡尺测量肿瘤长径与短径。
伦理终点设定:当肿瘤体积达1000mm³或出现溃疡时实施安乐死,并取出肿瘤进行后续处理分析检测。

4. 样本处理规范
液氮冻存组(-80℃过渡后长期保存,可提取蛋白质和RNA)。
福尔马林固定组(4%中性缓冲液固定24-48小时,用于免疫组化免疫荧光等实验) 。
同步留取血液样本(EDTA抗凝管)。
通过系统规避5大核心问题,结合标准化操作流程与质量控制体系,裸鼠皮下成瘤实验的成功率可稳定提升至90%以上。
中模生物现代实验动物中心,拥有成熟的皮下瘤模型构建服务体系,欢迎咨询了解~

